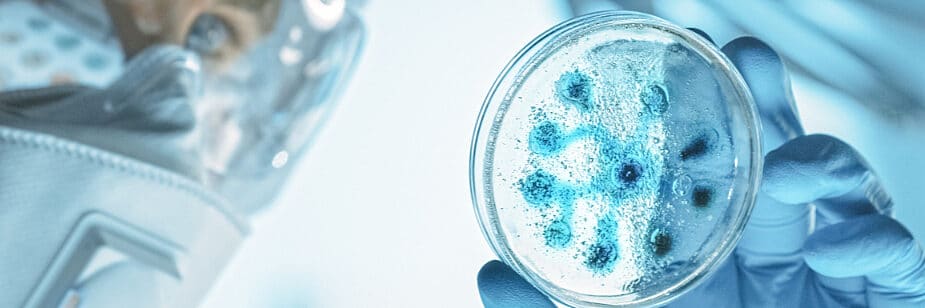

Vai prestar o Enem? Então você precisa manjar muito sobre o Reino Monera. Esse é um tema recorrente nas provas de todos os vestibulares. E o conhecimento cobrado vai muito além de suas características, viu?
É importante também que você conheça a relação entre as bactérias e a nossa saúde, seja nos prejudicando ou nos ajudando a realizar as funções essenciais de nosso organismo. Sim, é isso mesmo! Nem sempre esses microrganismos são problemáticos para gente, beleza?
Sendo assim, que tal batemos um papo sobre esse assunto? Continue a leitura e descubra um montão de coisas sobre o Reino Monera e esteja pronto para mandar bem na sua prova do Enem ou do vestibular!
- 1 O que é o Reino Monera?
- 2 Quais são as principais características do Reino Monera?
- 3 Qual é a relação entre o Reino Monera e o corpo humano?
- 4 Quais são as doenças causadas pelas bactérias?
- 5 O que estudar e como arrasar nessa parte da prova de Biologia no Enem?
- 6 Como o Reino Monera é visto e cobrado no Enem?
O que é o Reino Monera?
É uma divisão da Biologia que compreende os seres categorizados como bactérias e cianobactérias (estas também chamadas de algas azuis).
Quais são as principais características do Reino Monera?
As características gerais dos seres que compõem o Reino Monera são:
- unicelulares;
- não têm carioteca;
- possuem parede celular;
- podem ser autótrofos (produzir o próprio alimento) ou heterótrofos (precisar obter energia a partir de outra fonte);
- podem ter cílios e flagelos (para a locomoção);
- alguns podem ter uma cápsula que recobre a estrutura do ser;
- têm DNA circular em sua composição.
Além disso, há características específicas dos grupos. As bactérias, por exemplo, podem ser divididas quanto à sua estrutura — bacilos, cocos, espirilos e vibriões —, e as cianobactérias têm a capacidade de fazer fotossíntese.
A reprodução desse Reino é feita de maneira assexuada. O processo é conhecido como divisão binária, que forma seres iguais. A variabilidade genética é garantida a partir da conjugação, na qual acontece a troca de material genético.
Qual é a relação entre o Reino Monera e o corpo humano?
As bactérias são geralmente vistas como seres nocivos, mas a verdade é que elas são muito importantes para o corpo humano e a nossa vida como um todo. Algumas das formas que elas participam do nosso dia a dia são:
- o uso industrial e gastronômico, como na produção do ácido acético (vinagre) e o uso dos lactobacilos para a fermentação de iogurtes;
- a decomposição de matéria orgânica, fundamental para o ciclo da vida;
- as inúmeras bactérias do intestino, essenciais para a regulação do sistema digestivo e até para a proteção de nosso organismo.
Apesar disso, há, sim, doenças causadas por esses microrganismos. Vamos conhecê-las a seguir!
Quais são as doenças causadas pelas bactérias?
A seguir, confira algumas das doenças causadas por bactérias:
- pneumonia;
- infecção urinária (cistite);
- cáries nos dentes;
- sífilis;
- febre tifoide;
- gonorreia;
- meningite;
- hanseníase;
- tétano;
- brucelose;
- difteria;
- leptospirose;
- coqueluche;
- botulismo;
- cólera;
- clamídia.
Como vimos, há muitas doenças sexualmente transmissíveis entre as citadas. Por isso, é sempre legal você dar uma olhada especial nesse tema antes do seu vestibular!
Como essas doenças são combatidas?
As doenças bacterianas são combatidas com o uso de antibióticos. A descoberta da penicilina, primeiro medicamento do tipo a ser encontrado, foi um grande marco na Medicina.
Por que não devemos utilizar antibióticos indiscriminadamente?
O uso desses medicamentos é controlado pelos órgãos de saúde e, por isso, eles só são liberados mediante receita médica. Mas por que isso acontece?
O problema está na forma de usá-lo. Quando utilizamos os antibióticos por um tempo menor do que o prescrito pelo médico, selecionamos as bactérias mais resistentes ao remédio, deixando-as viver.
A partir da conjugação, há a troca de material genético. Assim, bactérias resistentes passam essa resistência também aos seus descendentes. Isso gera um problema muito sério, conhecido como as superbactérias, microrganismos que não respondem a praticamente nenhum antibiótico conhecido.
O que estudar e como arrasar nessa parte da prova de Biologia no Enem?
Agora, veja algumas dicas para estudar melhor esse assunto e se sair bem nas provas:
- entenda a teoria antes de passar para a resolução de exercícios;
- busque videoaulas diversas, a fim de encontrar um professor que o faça compreender o tema de maneira completa;
- desenhe as bactérias para entender a sua estrutura;
- use mapas mentais, flashcards e qualquer outro recurso que o ajude a memorizar suas características;
- resolva exercícios;
- relacione as bactérias com a saúde, citando tanto os seus benefícios como as doenças causadas por elas (importantíssimo para o Enem!);
- relacione o Reino Monera com outros reinos e entenda as suas diferenças e semelhanças.
Com essas dicas, a sua prova de Biologia no Enem vai estar no papo!
Como o Reino Monera é visto e cobrado no Enem?
Por fim, veja agora um exemplo de exercício sobre o Reino Monera que já foi cobrado em um vestibular. Vamos lá?
(VUNESP) Parte da população brasileira vive na periferia das grandes cidades, onde os serviços de saneamento básico, como sistema de esgoto e coleta do lixo, são precários. Nesses ambientes, podem ser observadas com facilidade as características seguintes:
I. locais com água parada;
II. aumento da população de ratos;
III. liberação de esgotos a céu aberto.
Assinale a alternativa que lista, respectivamente, as doenças que estão associadas a essas características.
a) I – febre amarela, causada por uma bactéria transmitida por mosquito que se reproduz em água parada; II – doença de Chagas, cujo protozoário causador utiliza ratos como transmissores; III – febre maculosa, cujas bactérias se concentram em água contaminada.
b) I – dengue, causada por uma bactéria transmitida por um mosquito que se reproduz em água parada; II –
toxoplasmose, cujos ratos são vetores; III – tétano, causado por bactérias que se concentram em água contaminada.
c) I – dengue, causada por vírus transmitido por um mosquito que se reproduz em água parada; II –leptospirose, causada por uma bactéria transmitida por ratos; III – cólera, causada por uma bactéria que pode ser ingerida com água ou alimentos contaminados.
d) I – doença de Chagas, cujo transmissor se reproduz em água parada; II – cólera, causada por uma bactéria transmitida por ratos; III – leishmaniose, causada por protozoários que se concentram em água contaminada.
e) I – hepatite A, causada por vírus presentes em água parada; II – amebíase, causada por amebas que são transmitidas por ratos; III – sífilis, causada por bactérias que se concentram em água contaminada.
Resposta: letra c.
Lembrando que errar a questão não é um problema. O problema é apenas deixar esse erro para trás! Compreenda os motivos pelos quais errou, entenda isso e utilize essa oportunidade para aprender mais. Faça isso com todos os exercícios — faz parte do processo de fixação do conteúdo e aprendizado!
Agora é com você!
Gostou de aprender mais sobre o Reino Monera? Agora, não pare por aí! Compreender mais sobre esse assunto é um processo contínuo na jornada rumo ao vestibular. E, claro, você precisa também conhecer os outros Reinos da Biologia. Confira mais informações em nosso blog!
Aliás, que tal saber mais sobre o Enem 2021? A prova está se aproximando e é hora de conseguir todas as informações sobre o exame!